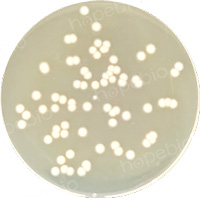

用途:用于铜绿假单胞菌的选择性增菌培养
成分(g/L)
明胶胨
|
16.0
|
胰蛋白胨
|
10.0
|
硫酸钾
|
10.0
|
氯化镁
|
1.4
|
溴化十六烷基三甲铵
|
0.2
|
萘啶酮酸
|
0.015
|
pH值7.1±0.2
|
25℃
|
检验原理:
明胶胨和胰蛋白胨提供氮源;硫酸钾和氯化镁可促进绿脓色素的产生;萘啶酮酸抑制非假单胞菌的革兰氏阴性杆菌。
用法:
称取本品37.6g,加热溶解于1000ml蒸馏水中,分装,121℃高压灭菌15分钟,备用。
质控菌株菌悬液在TSA上的计数结果

|

|
铜绿假单胞菌ATCC 9027
|
铜绿假单胞菌ATCC 27853
|
|

|

|
大肠埃希氏菌ATCC 25922
|
金黄色葡萄球菌ATCC 6538
|
空白对照
|
铜绿假单胞菌增菌肉汤微生物灵敏度试验:
按标签用法制备培养基,接种以下质控菌株,放置36±1℃需氧培养18-24小时。

相关资料:
铜绿假单胞菌增菌肉汤的原理和使用方法 点击查看